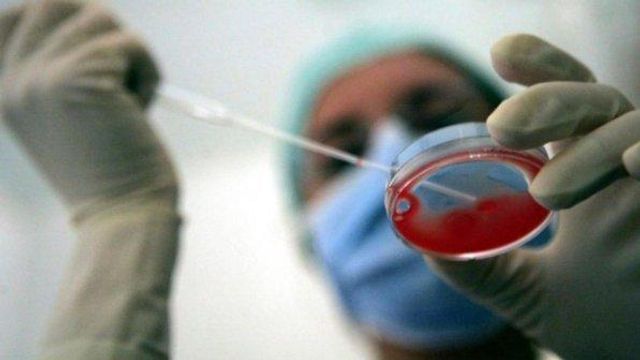

L'ospedale pediatrico Gaslini di Genova è il primo centro mondiale a somministrare, in via sperimentale, un nuovo farmaco in grado di bloccare l'insorgenza della fibrodisplasia ossificante progressiva, conosciuta anche come "Sindrome dell'uomo di pietra", che genera l'ossificazione di muscoli, tendini e legamenti. Sono italiane di età compresa tra i 18 e i 20 anni e tutte in cura al Gaslini le primi quattro pazienti arruolate per la sperimentazione avanzata.
La Fop è una malattia rarissima e al momento senza cura che colpisce una persona su 2 milioni. In Italia ci sono 34 casi.
La malattia, che ha insorgenza spontanea o in risposta a particolari stimoli (in genere traumi), trasforma muscoli e tendini in ossa: si forma in questo modo un secondo scheletro sopra al primo, portando il paziente ad essere come rinchiuso in una gabbia di ossa. Quando la malattia raggiunge il torace comporta gravi problemi respiratori, che possono di portare il paziente al decesso.
La malattia è dovuta a una mutazione del gene di un recettore posto sulla superficie della cellula. A causa della mutazione il recettore diventa capace di legare l'activina, una proteina che abitualmente non lega: in conseguenza di questo legame si innescano una serie di eventi che comportano la formazione di osso in muscolo, tendini, legamenti. Una condizione altamente invalidante e a oggi incurabile: ogni qual volta si cerca di rimuovere chirurgicamente queste formazioni ossee, si scatena un’ulteriore ossificazione, ancor più aggressiva della precedente.
La sperimentazione del farmaco, studiato in un laboratorio di ricerca americano, è iniziata al Gaslini e nelle prossime settimane vedrà coinvolti anche la Mayo Clinica in America e il Royal National Orthopaedic Hospital in Gran Bretagna. La nuova terapia, di cui i risultati sull'efficacia si avranno tra due anni, è un anticorpo monoclonare che dovrebbe non solo prevenire ulteriori ossificazioni nei malati ma anche dare la possibilità di rimuovere le ossificazioni esistenti senza che si riformino.
"Qui al Gaslini inizia la sperimentazione di fase due - ha detto Maja Di Rocco, responsabile di Malattie rare dell'ospedale pediatrico genovese -. Il farmaco è già stato sperimentato a livello animale e in questa fase la sperimentazione serve per verificarne l’effettiva efficacia. Lo studio durerà due anni. Attualmente abbiamo quattro ragazze, le prime al mondo, a cui stiamo somministrando la terapia".
Per il direttore generale del Gaslini, Paolo Petralia, "si tratta di un ottimo risultato di cui andiamo orgogliosi, un lavoro frutto delle collaborazione delle diverse professionalità del nostro istituto, attualmente unico centro italiano di riferimento per questa patologia. Lo studio clinico di un farmaco per un malattia così rara è un messaggio di speranza per i malati".